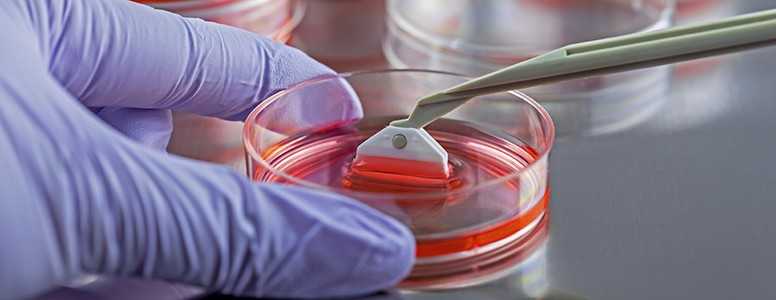

A start-up from Cambridge, Massachusetts in the US, has raised $114m (£87.4m) of funding to run human trials of a novel encapsulation device designed to treat type 1 diabetes.
Semma Therapeutics has been founded by celebrated Harvard researcher, Professor Doug Melton. His work includes a breakthrough stem cell method that is able to generate billions of working beta cells to produce insulin.
Semma has teamed up with French company Defymed which has developed an encapsulation device called MailPan. The device is BioArtificial Pancreas (BAP) which is able to hold working beta cells within the body.
The device is implanted with initial surgery but is able to let old beta cells out and take new ones in preventing the need for follow-up surgery. Specialist membranes intend to keep the beta cells working whilst protected from the immune attack of type 1 diabetes.
Semma has received its funding from a variety of sources including the JDRF T1D Fund, insulin pump manufacturer Medtronic, and Swiss pharmaceutical Novartis.
The company’s founder has a very personal reason for dedicating to his work. He has both a son and daughter with type 1 diabetes. After initially working on frog’s eggs at Harvard, Prof. Melon turned his expertise to studying stem cells in a bid to find a working treatment for the condition his children had developed.
To date, Semma’s stem cell treatments have worked in mice and rats. The next step is to test the treatment on humans and the latest funding round will help towards this aim.
Prof. Melton stated his optimism about the future of diabetes treatment: “Semma’s scientists have very effectively dedicated themselves to systems that reliably generate cells indistinguishable from human pancreatic beta cells and to the invention of novel devices that are immunologically protective and surgically practical. We’re very encouraged and excited about the potential this program has for diabetic patients and their families.”
What's new on the forum? ⭐️
Get our free newsletters
Stay up to date with the latest news, research and breakthroughs.